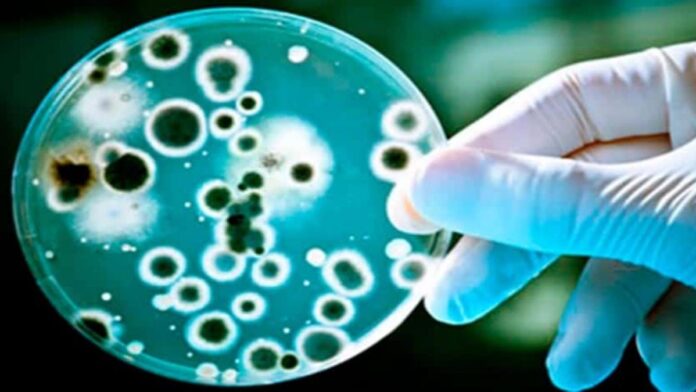

Você já parou pra pensar se existe uma doença infecciosa que ninguém sobrevive? A pergunta parece coisa de filme de terror, mas a ciência leva isso bem a sério. E olha… a resposta é um sonoro sim — ainda que a boa notícia seja que esses casos são raríssimos.
Quando o corpo não tem chance
A maioria das doenças infecciosas hoje pode ser tratada ou prevenida graças à medicina moderna. Tuberculose, covid-19, HIV, todas já tiveram fases bem mais mortais. Hoje, com vacinas, antibióticos e antivirais, a gente tem bem mais chance de sair vivo do outro lado.
Mas existem aquelas doenças sinistras, que ainda não deram espaço pra ciência entender como vencê-las. E quando elas aparecem, praticamente ninguém escapa.
A campeã do terror: ameba comedora de cérebro 🧠
Pode parecer brincadeira, mas existe uma ameba chamada Naegleria fowleri que pode entrar pelo seu nariz quando você nada em água doce quente e contaminada — tipo lagoas ou piscinas mal tratadas. Uma vez dentro do corpo, ela sobe até o cérebro e começa a devorar o tecido cerebral.
O nome é assustador e a taxa de mortalidade também: mais de 97%. Só um punhado de pessoas no mundo sobreviveu a essa infecção até hoje, e geralmente por causa de diagnóstico super precoce + tratamento agressivo.
Príons: as proteínas assassinas 🧬
Outro exemplo são as doenças causadas por príons, como a famosa Doença da Vaca Louca (variante da Creutzfeldt-Jakob). Essas doenças envolvem proteínas deformadas que infectam o cérebro e causam uma degeneração progressiva e devastadora.
Não tem cura. Não tem tratamento eficaz. E, na maioria dos casos, o fim é inevitável.
LEIA MAIS:
- O que a cor da urina pode revelar sobre sua saúde
- Saiba 5 doenças que o suco de banana pode “curar”
- Confira 5 dicas de como emagrecer rápido e de forma saudável

O pior? Alguns casos acontecem de forma hereditária, mas também é possível contrair a doença por meio de carne contaminada ou procedimentos médicos que envolvam tecidos cerebrais infectados.
Por que algumas doenças são tão fatais?
A ciência acredita que essas doenças extremamente letais nos pegam desprevenidos porque nós não somos os hospedeiros naturais desses patógenos. Ou seja, nosso sistema imunológico não teve tempo (e nem motivo) pra desenvolver defesas contra eles. E como esses organismos também não “querem” conviver com a gente — eles matam o hospedeiro rápido demais —, a evolução não criou um equilíbrio.
Resultado: um ataque rápido, agressivo e quase sempre fatal.
A melhor arma? Prevenção🛡️
A verdade é que, mesmo com todo o avanço da medicina, algumas doenças continuam no modo “chefão final”. E a única forma de não cair nessa cilada é com prevenção: evitar nadar em águas suspeitas, cozinhar bem os alimentos, manter a higiene e, claro, estar atento a sintomas estranhos.